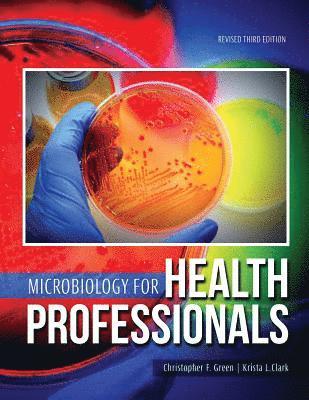

The contributors to this volume seek further understanding of the microfoundations of economic growth. It focuses on three subjects that interested the great Austrian and Harvard economist, Joseph A. Schumpeter: innovation, technological change, and economic growth. The first part of the volume treats institutions, markets, and entrepreneurs, without which analysis of the firm makes little or no sense. The second part focuses on the firm as innovator, placing heavy emphasis on the role of knowledge formation. The subjects of innovation and knowledge formation are approached from three perspectives: theoretical; industry (case) studies; and empirical (cross section and panel data) analysis. In the third part of the book the action moves from the firm to the "macro" or economy-wide level. The volume's unique feature is combining institutions, the innovative behavior of firms, and an intuitively dynamic, macroeconomic analysis, all from a Schumpeterian perspective. It is argued that the study of micro-institutions such as firms and the evolving nature of markets are necessary ingredients to understanding macro-oriented phenomena such as economic growth. It is in this sense, then, that the book is concerned with microfoundations. Contributors are Daniele Archibugi, Spyros Arvanitis, David B. Audretsch, John R. Baldwin, Gerard Ballot, Pontus Braunerhjelm, Dagobert L. Brito, Uwe Cantner, Bo Carlsson, Robert W. Clower, Richard Day, Rinaldo Evangelista, Jan Glete, Horst Hanusch, Heinz Hollenstein, Michael D. Intrilgator, George Johnson, Joanne Johnson, Aija Leiponen, Staffan Laestadius, Richard N. Langlois, Frank M. Machovec, Maureen McKelvey, Valentina Meiciani, Douglass C. North, Giulio Perani, Andreas Pyka, Fabio Rapiti, Roberto Simonetti, Frank Stafford, Paula E. Stephan, Erol Taymaz, Clas Wihlborg, Erica R. Worth, and S. Y. Wu. Gunnar K. Eliasson is Professor of Industrial Economics, Royal Technical Institute (KTH), Stockholm. Christopher Green is Professor of Economics, McGill University. Charles R. McCann, Jr., is Research Associate, Department of Economics, University of Pittsburgh.